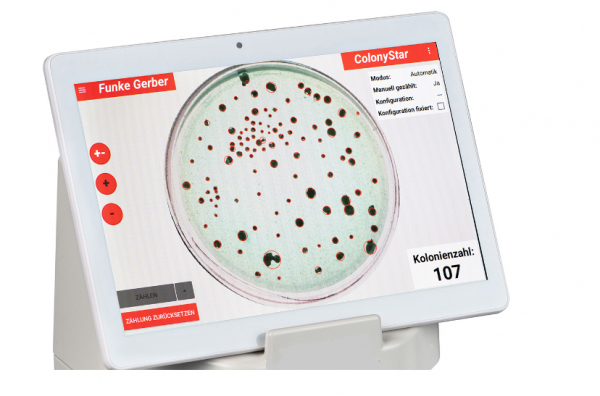

| Sign In | Join Free | My frbiz.com |
|
- Home
- Products
- About Us
- Quality Control
- Contact Us
- Get Quotations
| Sign In | Join Free | My frbiz.com |
|
Brand Name : HiYi
Model Number : ColonyStar
Certification : CE
Place of Origin : China
MOQ : 1
Payment Terms : L/C, D/A, D/P, T/T, Western Union, MoneyGram
Delivery Time : 15 work days
Packaging Details : paper case
Protection : II
Protection type : IP20
Operation temperature : 5 °C - + 40 °C
Storage temperature : -10 °C - + 60 °C
Systems software (Tablet) : Systems software (Tablet)
Power max. (Power supply Tablet) : 10 W
ColonyStar Colony Counter
ColonyStar automatic complete with scanner and tablet computer standard. This device is suitable for all petri dishes within the food industry but also in medicine and all other areas in microbiology and therefore widely applicable. It significantly reduces the work in the laboratory. The device can be operated with single-shot, semi-automatic or fully automatic mode.
Tecnical specifications:
| Input voltage (Power supply of the ColonyStar Scanner) | 100 - 240 VAC |
| Frequency (Power supply ColonyStar Scanner) | 50 - 60 Hz |
| Power max. (Power supply ColonyStar Scanner) | 24 W max. |
| Output voltage (Power supply ColonyStar Scanner) | 24 VDC |
| Input voltage (Power supply Tablet) | 100 - 240 VAC |
| Frequency (Power supply Tablet) | 50 - 60 Hz |
| Power max. (Power supply Tablet) | 10 W |
| Output voltage (Power supply Tablet) | 5 VDC |
| Tablet-Display | 10“ (254 mm) |
| Systems software (Tablet) | Android |
| Protection | II |
| Protection type | IP20 |
| Operation temperature | 5 °C - + 40 °C |
| Storage temperature | -10 °C - + 60 °C |
| Dimensions (ColonyStar Scanner) | 186 x 155 x 197 mm (LxBxH) |
| Weight (ColonyStar Scanner + Tablet) | 1665 g |

|
|
Colonystar Colony Counter Machine Standard In Medicine Areas Microbiology Images |